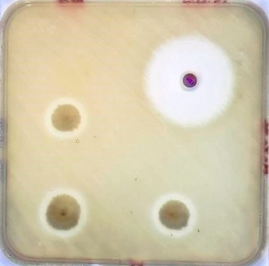

How Enviro Spore Microbes Work on Your Farm

The Microbial Advantage
-
Your bedding and soil naturally host bacteria, good and bad.
-
Enviro Spore adds beneficial Bacillus and Lactobacillus strains that:
-
Outcompete pathogens for space and food
-
Form resilient biofilms
-
Produce antimicrobial peptides to actively suppress harmful bacteria

In the Bedding
-
Breaks down organic waste faster
-
Reduces moisture and ammonia
-
Creates a cleaner environment for better footpad health and lower odour
-
Primes gut health by reducing early-life pathogen pressure
Antimicrobial Peptides (AMPs)
-
Enviro Spore strains are known to produce peptides that disrupt harmful bacteria membranes
-
Unlike chemicals, these are natural and selective, leaving good microbes intact

Long-Term Benefits
-
Lowers Cost of production
-
Residual microbes in used litter benefit compost and soil
-
Builds microbial resilience crop after crop. Inhibits AMR (antimicrobial resistance) buildup Enviro Spore works by microbial competition and natural peptides. This helps reduce reliance on medicated inputs and slows down the development of antimicrobial resistance in farm environments.
-
Improves downstream soil health
Spent litter from treated sheds contains active microbes that boost composting, reduce nitrogen loss, and enrich soil biology when spread on land. -
Supports regenerative hygiene
With every cycle, beneficial bacteria establish deeper in your house environment, improving litter quality, early gut health and setting up the next crop for success.

Want to See the Results for Yourself?
Get access to technical data, independent test results, and real-world case studies.
📄 Includes:
-
E. coli reduction figures
-
FCR improvements
-
Before-and-after footpad scores
-
Soil impact following litter application
